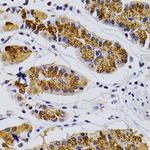
CDK7 Antibody in Immunohistochemistry (Paraffin) (IHC (P))

Search
Invitrogen
CDK7 Polyclonal Antibody
{{$productOrderCtrl.translations['antibody.pdp.commerceCard.promotion.promotions']}}
{{$productOrderCtrl.translations['antibody.pdp.commerceCard.promotion.viewpromo']}}
{{$productOrderCtrl.translations['antibody.pdp.commerceCard.promotion.promocode']}}: {{promo.promoCode}} {{promo.promoTitle}} {{promo.promoDescription}}. {{$productOrderCtrl.translations['antibody.pdp.commerceCard.promotion.learnmore']}}

Please note: We are reviewing Western blot images included in the antibody testing data in our catalog, including those provided by third parties. Unless expressly labeled or annotated as “raw-unedited”, Western blot images included in the antibody testing data in our catalog may have been edited, optimized or otherwise adjusted for presentation.
产品信息
PA5-95857
种属反应
宿主/亚型
分类
类型
抗原
偶联物
形式
浓度
规格
纯化类型
保存液
内含物
保存条件
运输条件
RRID
产品详细信息
Immunogen sequence: MALDVKSRAK RYEKLDFLGE GQFATVYKAR DKNTNQIVAI KKIKLGHRSE AKDGINRTAL REIKLLQELS HPNIIGLLDA FGHKSNISLV FDFMETDLEV IIKDNSLVLT PSHIKAYMLM TLQGLEYLHQ HWILHRDLKP NNLLLDENGV LKLADFGLAK SFGSPNRAYT HQVVTRWYRA PELLFGARMY GVGVDMWAVG CILAELLLRV PFLPGDSDLD QLTRIFETLG TPTEEQWPDM CSLPDYVTFK SFPGIPLHHI FSAAGDDLLD LIQGLFLFNP CARITATQAL KMKYFSNRPG PTPGCQLPRP NCPVETLKEQ SNPALAIKRK RTEALEQGGL PKKLIF; Positive Samples: Mouse heart; Cellular Location: Cytoplasm, Nucleus, perinuclear region
靶标信息
The trimeric complex of CDK7, cyclin H and MNAT1, functions as a Cdk-activating kinase (CAK). It is an essential component of the transcription factor TFIIH, that is involved in transcription initiation and DNA repair. This complex is thought to serve as a direct link between the regulation of transcription and the cell cycle. The bound complex is important in the normal double-strand break repair function of breast cancer, type 1 (BRCA1). CDK7 may be a target of germline cancer-inducing mutations.
仅用于科研。不用于诊断过程。未经明确授权不得转售。
篇参考文献 (0)
生物信息学
蛋白别名: 39 KDa protein kinase; CAK; CDK; CDK-activating kinase; CDK-activating kinase 1; Cell division protein kinase 7; CR4 protein kinase; CRK4; CRK4 PK (CDC2-related-kinase-4 protein kinase); Cyclin-dependent kinase 7; cyclin-dependent kinase 7 (homolog of Xenopus MO15 cdk-activating kinase); cyclin-dependent kinase 7 (MO15 homolog, Xenopus laevis, cdk-activating kinase); EC 2.7.11.22; EC 2.7.11.23; homolog of Xenopus MO15 Cdk-activating kinase; kinase subunit of CAK; OTTHUMP00000222032; OTTHUMP00000222033; P39 Mo15; Protein-tyrosine kinase MPK-7; serine/threonine kinase stk1; serine/threonine protein kinase 1; serine/threonine protein kinase MO15; Serine/threonine-protein kinase 1; TFIIH basal transcription factor complex kinase subunit
基因别名: AI323415; AI528512; C230069N13; CAK; CAK1; CDK7; CDKN7; Crk4; HCAK; MO15; Mpk-7; p39MO15; STK1
UniProt ID: (Mouse) Q03147
Entrez Gene ID: (Human) 1022, (Mouse) 12572




